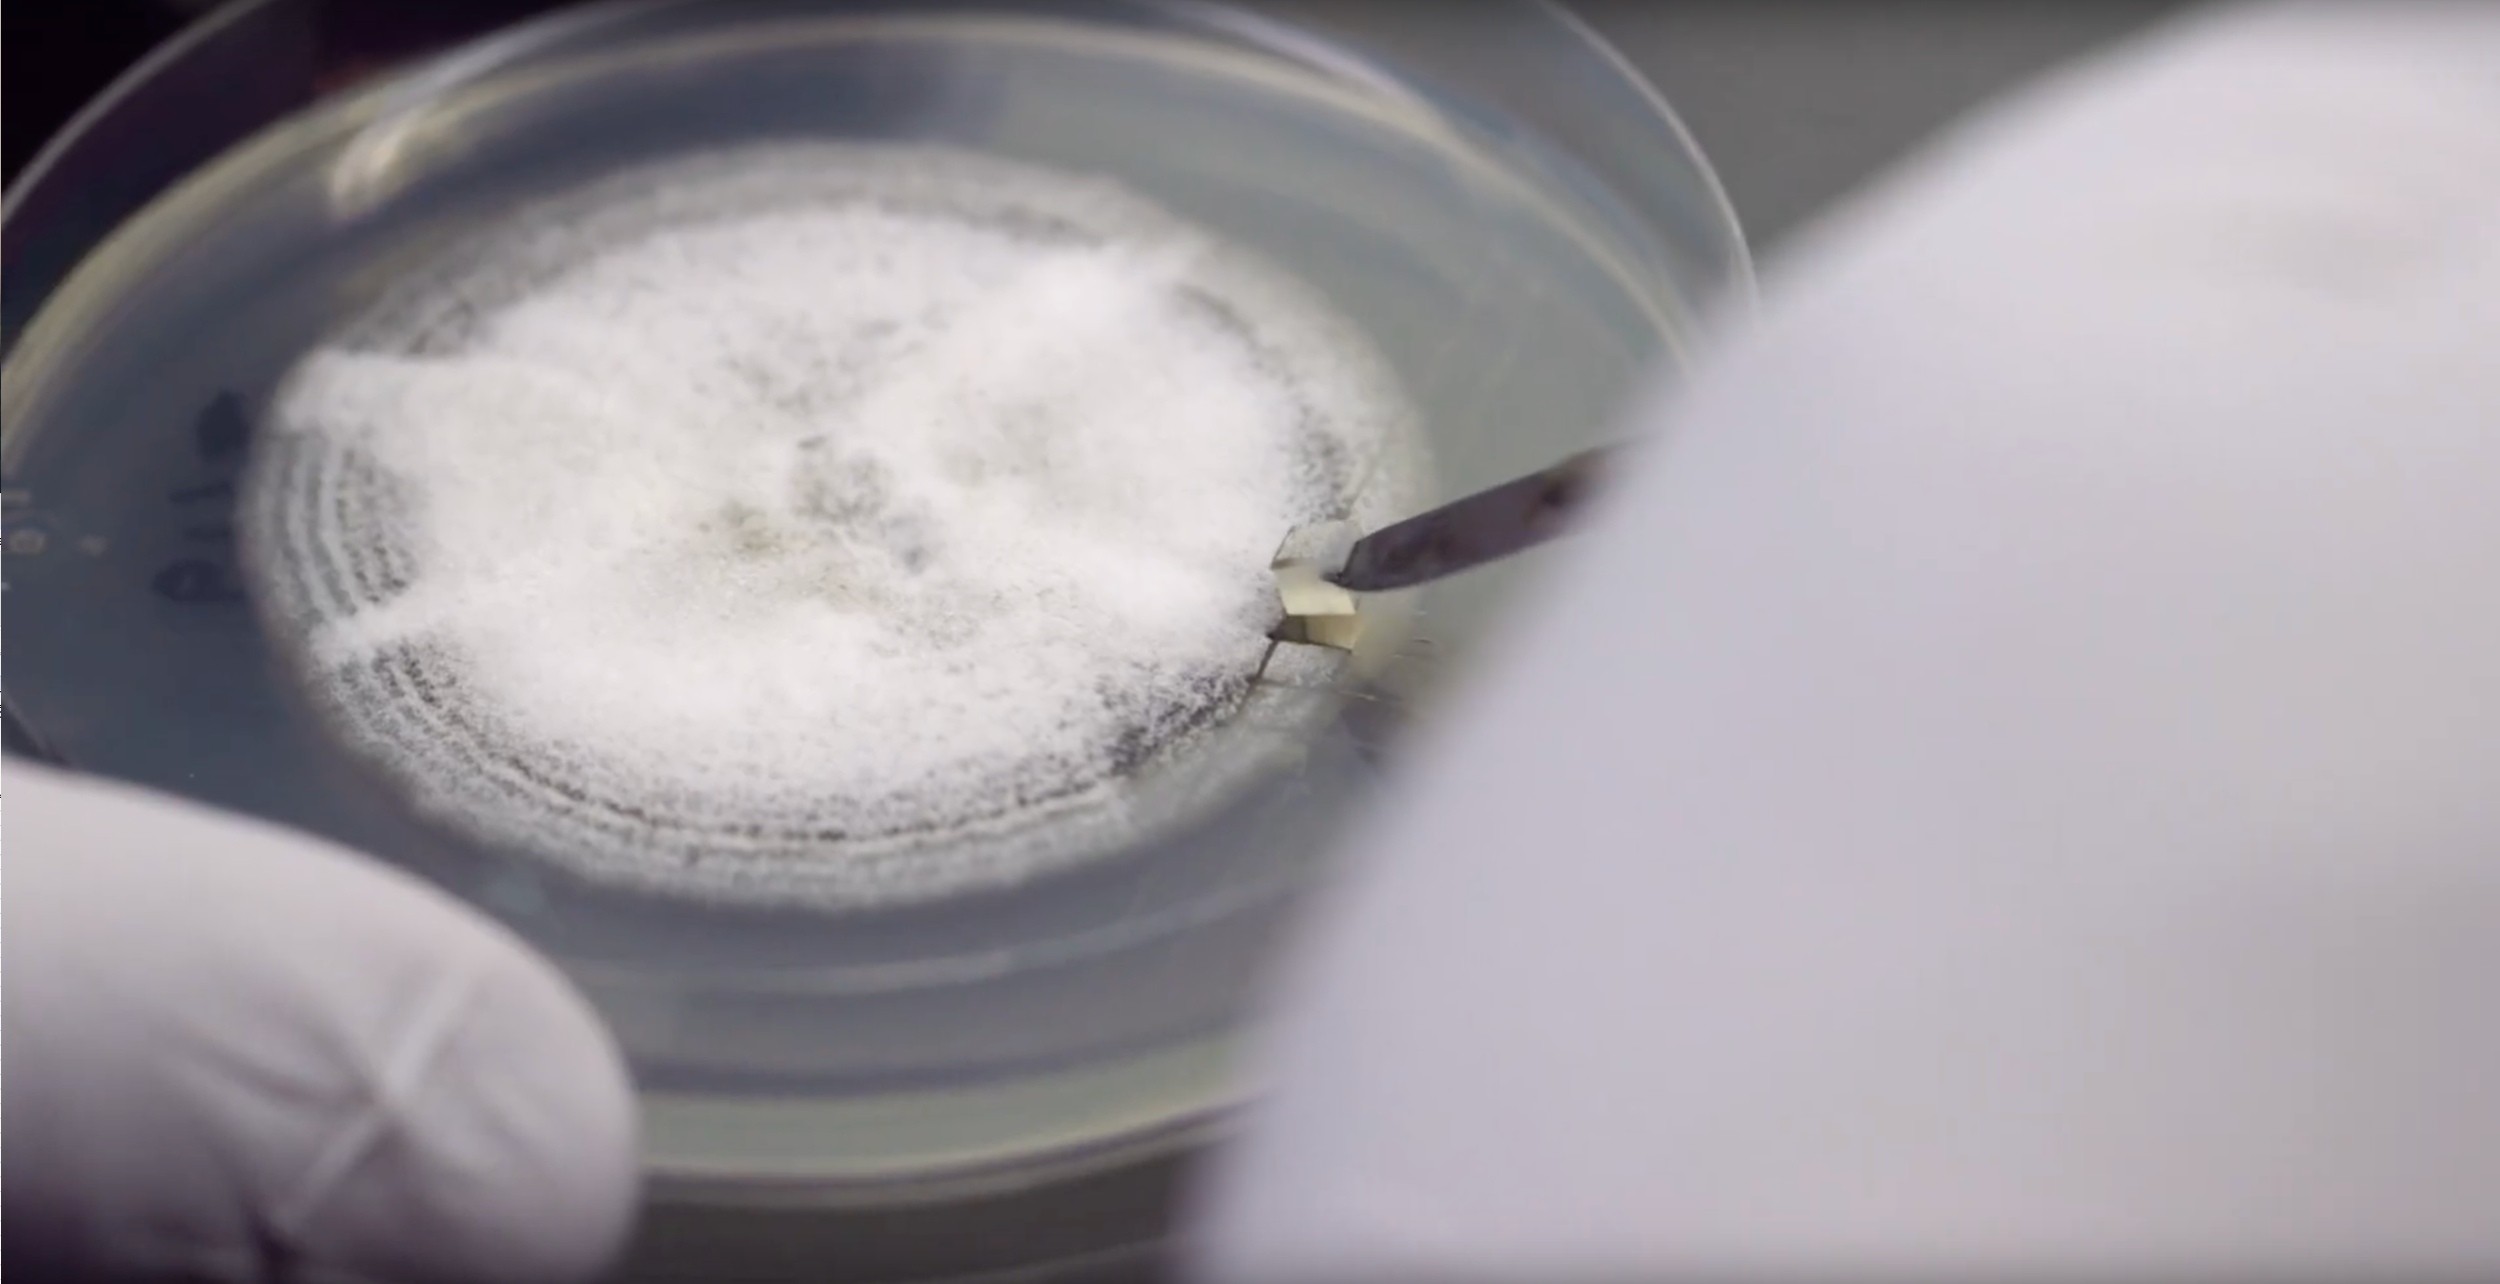

“The First Crop: Emerging Organic Leaders”
Recruitment is hard - you have a great program but how can you help the small army of potential students see themselves applying? That was the challenge that The UW Organic Collaborative was facing. To meet it head-on, we built a series of student vignettes that lets potential applicants see the real people doing real, world-helping work at UW, and therefore be able to see themselves joining in. A visual message: The water is warm - jump in!
Production Credits
Director: Anders Gurda
Editors: Anders Gurda and Ryley Hartwig
Production Company: Freestone Media